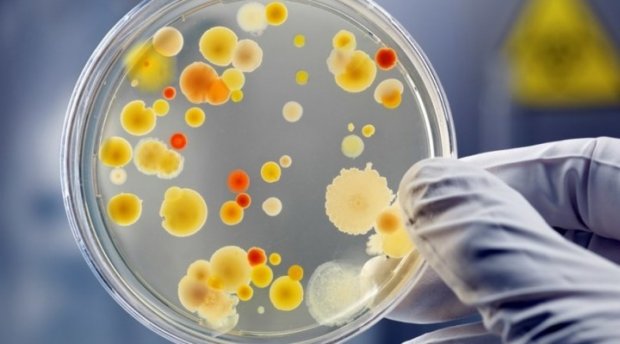

Уй ҳайвони сиз ўйлаганингиздан-да кўпроқ муаммо келтириб чиқариши мумкин. Гап шундаки, ҳатто оддий мушук ва итлар ҳам кўпинча инсон учун ҳалокатли тугаши мумкин бўлган касалликларнинг "етказувчилари" бўлиши мумкин. Шифокорлар бундай касалликларни алоҳида гуруҳга ажратишади - зооантропонозлар - унга тахминан юз хил касаллик киради. Don't Panic тақдим этган мавзуга оид мақолани ўқиб кўринг ва хулоса қилинг, уйингизда жониворларни сақлаш ҳаётингизни гаровга қўйишингизга арзирмикан?!
Қутуриш
Уй ҳайвони бу касалликни ёввойи ҳайвонлардан юқтириши мумкин. Қутуриш инсон учун ўта хавфли: вирусни вакцинасиз даволаб бўлмайди ва бу ўлим билан тугайди.
Токсоплазмоз
Ит ва мушуклардан юқувчи паразитар касаллик. Унинг енгил шакли деярли хавфсиз, бироқ оғир шакли жигарнинг токсик шикастланиши, фалаж ва ўлимга олиб келиши мумкин.
Лептоспироз
Лептоспирозни халқ орасида ит тифи дейишади, бироқ ҳар қандай сут эмизувчи уни юқтириб олиши мумкин. Инсон бу касалликни одатда касалланган жониворнинг суви, сўлаги ёки пешобидан юқтириши мумкин. Лептоспироз жигар ва юракка ҳужум қилади.
Атипик пневмония
Экзотик жониворлар - экзотик касалликлар. Инсоният биринчи бўлиб атипик пневмонияни виверра - Жануби-Шарқий Осиё йиртқичидан юқтирган. Вируснинг янги турлари уй ҳайвонларида ҳам кузатилмоқда.
ОИТС
Бу касалликни инсонга Марказий Африка маймунлари юқтиришган. Вирус бугунги кунда ҳам ҳайвонлар орқали юқиши мумкин.
Лайм касаллиги
Лайм касаллиги белгилари оддий тумов белгиларига жуда ўхшаш. Агар касаллик вақтида аниқланмаса, асоратлари жуда аянчли бўлади, фалаж ҳам шулар сирасига киради.
Гельминтозлар
Бу гельминтлар, паразит гижжалар орқали юқувчи касалликларнинг умумий номи. Уй ҳайвонларининг тахминан 57 фоизи - гельминт ташувчилари. Инсоннинг паразитларни юқтириши осон, бироқ уни даволаш қийин ва жуда ёқимсиз.
Манба: Sof.uz «Замин»ни Telegram’да ўқинг!
Ctrl
Enter
Хато топдИнгизми
Иборани ажратиб Ctrl+Enter тугмасини босинг Мавзуга оид янгиликлар